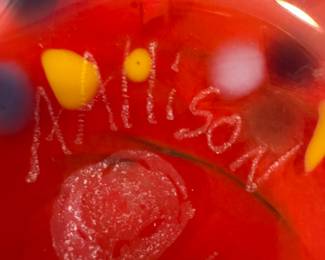
Sale Picture

MAGNIFICENT ESTATE COLLECTION
by appointment | 1 day sale | sale is over
Address
This sale in Dallas, TX 75225 is a "By Appointment" sale. Please see sale info below for details. Dates
Sat
Jan 3
10am to 3pmTerms & Conditions
Have to make an appt to preview and buy Saturday Jan 3rd 10-3 please text
214-228-7318
So many beautiful and rare collectibles loads of unique small objects .
214-228-7318
So many beautiful and rare collectibles loads of unique small objects .

Rooms With A View
Description & Details
Make an appt today to view and purchase items from this MAGNIFICENT ESTATE COLLECTION. Saturday January 3rd 10-3 If something catches your eye please text and will try to accommodate pre-sales with pricing.

Thank you for using EstateSales.NET. You're the best!